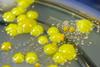
M-luteus-Micrococcus-luteus

All Tim Sandle (Bio Products Laboratory) articles
-
 Article
ArticleMicrobiology/RMM In-Depth Focus 2025
This in-depth focus features articles on rapid microbiological methods, quality control, and using AI to read agar plates.
-
 Article
ArticleEuropean Pharmaceutical Review Issue 3 2025
EPR Issue 3 includes articles on microbiology, downstream processing, manufacturing, drug formulation and more.
-
 Report
ReportPharma Horizons: Artificial Intelligence
EPR’s inaugural Pharma Horizons report explores the latest advances in artificial intelligence (AI) and machine learning (ML) for drug development, pharmaceutical manufacturing and quality control.
-
 Article
ArticleYear in review: EPR’s top stories of 2023
EPR wraps up the year with a selection of top stories from 2023, highlighting key trends and topics such as environmental monitoring (EM), quality (QA/QC), manufacturing, regulation and clinical development.
-
News
NewsStarvation stress key in Micrococcus luteus cleanroom survival
Key factors behind the lengthy survival capabilities of the bacterium Micrococcus luteus (M. luteus) within a cleanroom have been reported in Tim Sandle’s recent paper.
-
 Article
ArticleDeveloping an effective contamination control strategy
A key part of Annex 1, due to come into effect on 25 August 2023, is the development of a holistic contamination control strategy (CCS). In this article, EPR’s Caroline Peachey summarises an expert panel discussion, which explored common challenges in implementing a CCS and made several recommendations.
-
 News
NewsIdentifying origin of fungi in cleanrooms
Microbiology expert Tim Sandle’s recent video examined identifying the origin of fungi in pharmaceutical cleanrooms.
-
 Article
ArticlePharmaceutical microbiology: key developments 2022
Here, microbiology experts Tim Sandle, Tony Cundell and AstraZeneca’s Miriam Guest reflect on key developments in pharmaceutical microbiology during 2022.



